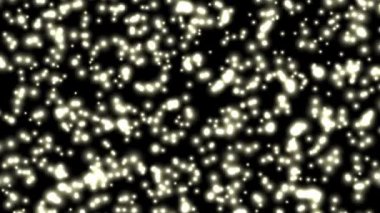
Geçiş efektinin 3d görüntülenmesi hareket grafiği için izole edildi

İhlal Bildirim Formu
En Çok Aranan Kelimeler
ArkaplandizayndekoratifparlakGüzellikSoyutParlahavaEnerjiIşıkDesenkabloDalgasembolSüzülfikiryumurtaparlayansaflıkKirlilikyıldızlarIşınCennetanalogzihinParçacıktozerimetitreşimlavheyecanlandırmakdarbelibeautiful-vjdream-backdropefemera-planktonyaratıcılık-sanatromantik-havai fişekmikrop-algbüyü-gökyüzüanimasyon-süslemebakteri hücrelerikabarcık-vizyonarıza-etkisimistik-gürültüfirefly parlakkar-tozlarSporlar-granülteknoloji-sinyaltelevizyon-hataSualtı GörsellerBenzer İçerikler